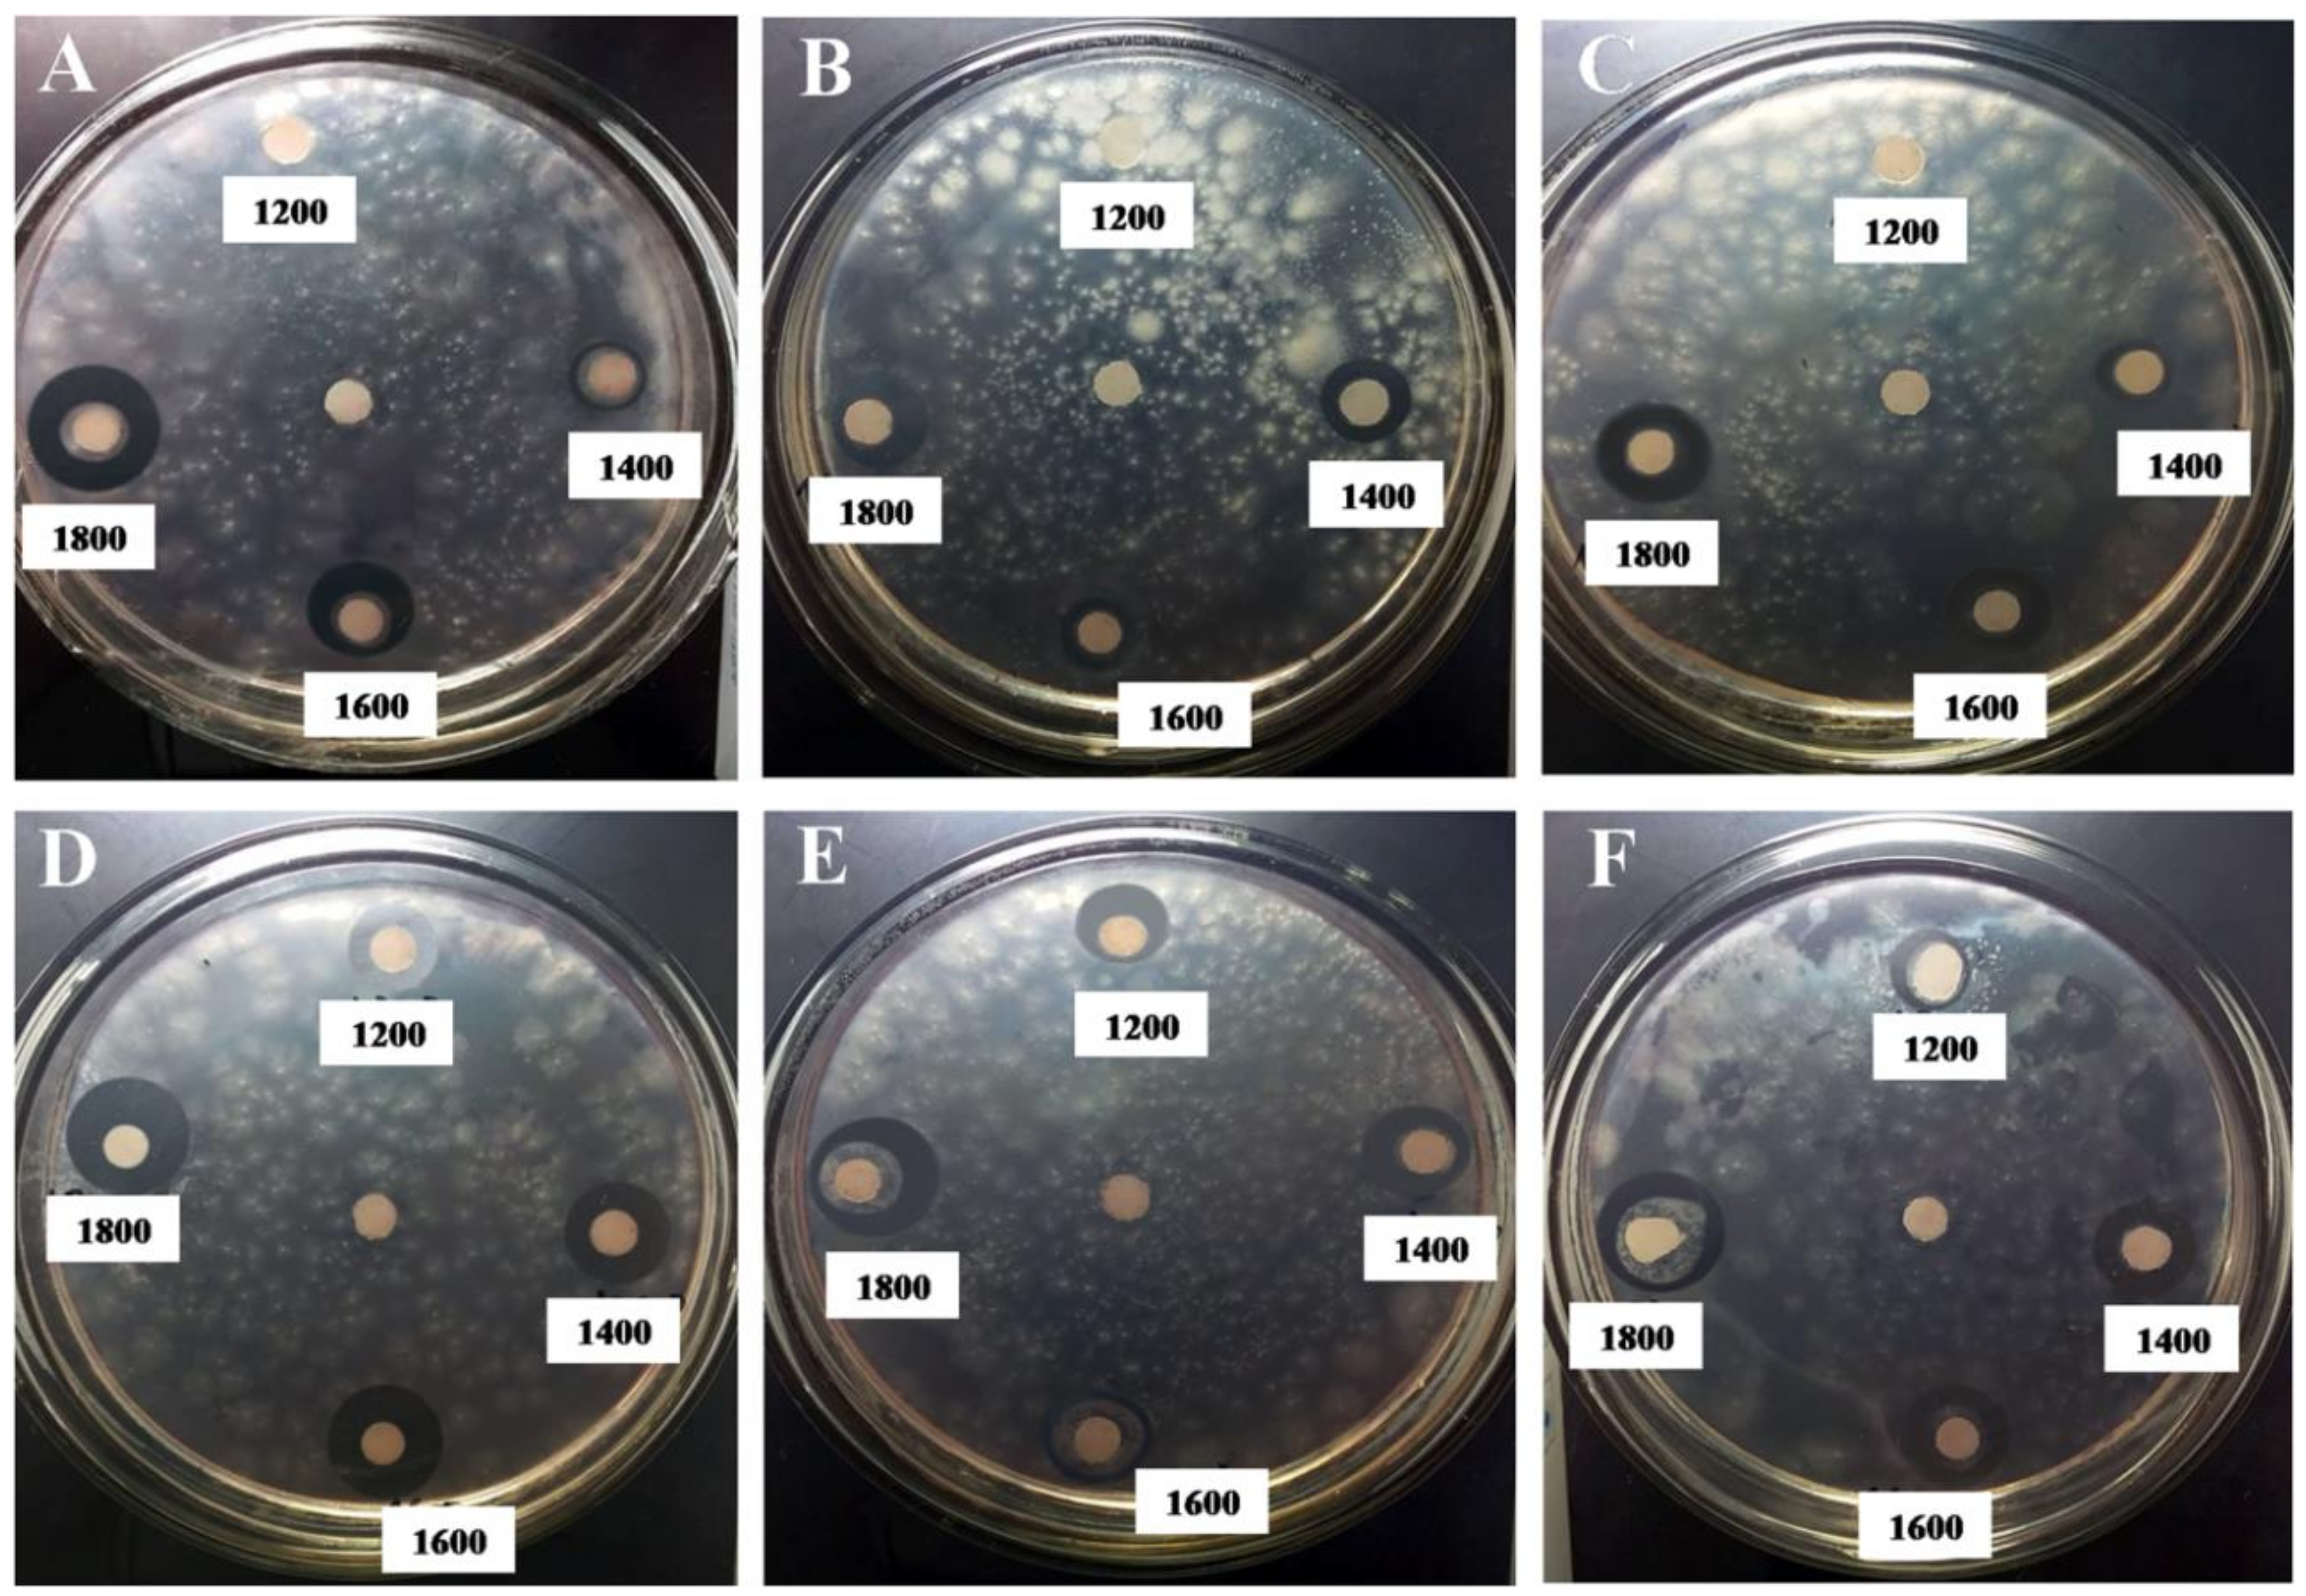
Polymers 11 00628 g005 550
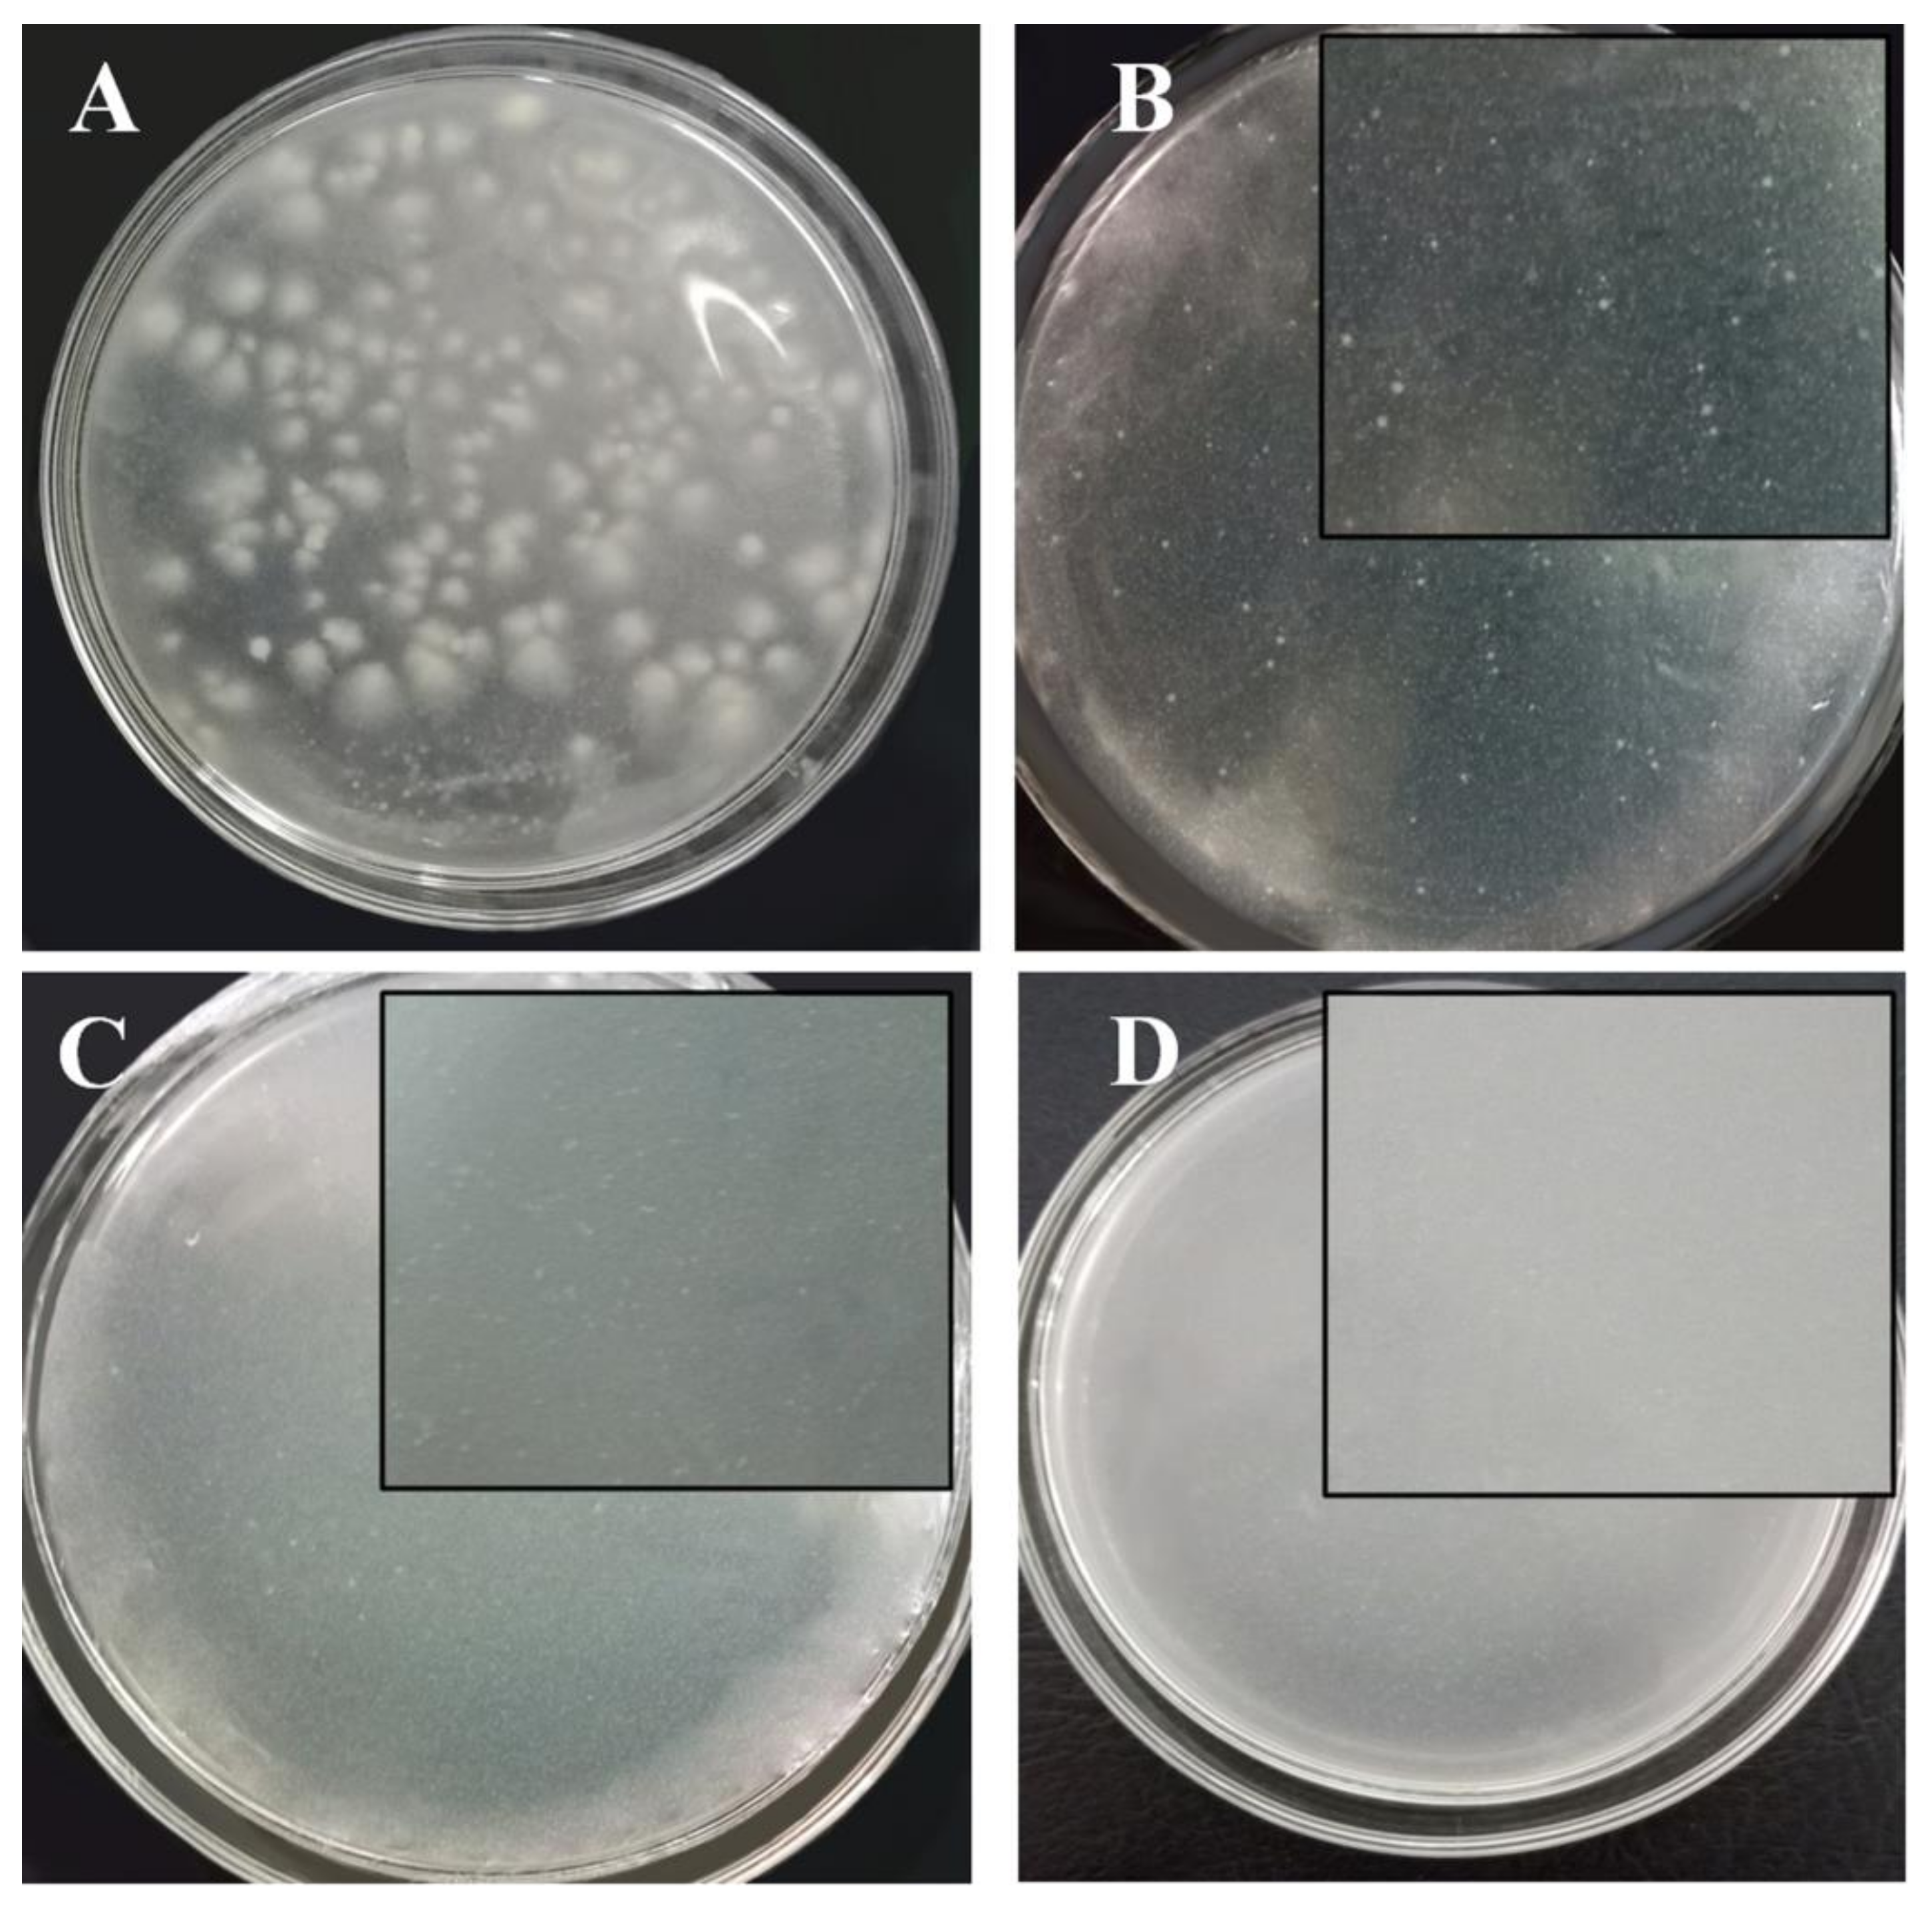
Polymers 11 00628 g007 550

Functional Nanostructured Oligochitosan–Silica/Carboxymethyl Cellulose Hybrid Materials: Synthesis and Investigation of Their Antifungal Abilities
Abstract
:1. Introduction
2. Materials and Methods
2.1. Materials
2.2. Preparation of Oligochitosan (OCS) with Different Molecular Weights
2.3. Preparation of Nanosilica (nSiO2) from the Rice Husk
2.4. Preparation of Hybrid Materials
2.5. Characterization and Measurements
2.6. Antifungal Effect Test on Phytophthora Infestans
2.7. Investigation of the Minimum Inhibitory Concentration (MIC)
3. Results and Discussion
3.1. Characterization of the Oligochitosan
3.2. Characterization of the Nanosilica
3.3. Characterization of the Hybrid Materials
3.4. Antifungal Effect Tests on Phytophthora Infestans
4. Conclusions
Author Contributions
Funding
Conflicts of Interest
References
- Kang, B.; Dai, Y.; Zhang, H.; Chen, D. Synergetic degradation of chitosan with gamma radiation and hydrogen peroxide. Polym. Degrad. Stab. 2007, 92, 359–362. [Google Scholar]
- Liang, S.; Sun, Y.; Dai, X. A review of the preparation, analysis and biological functions of chitooligosaccharide. Int. J. Mol. Sci. 2018, 19, 2197–2216. [Google Scholar]
- Qin, C.; Du, Y.; Xiao, L.; Li, Z.; Gao, X. Enzymic preparation of water-soluble chitosan and their antitumor activity. Int. J. Biol. Macromol. 2002, 31, 111–117. [Google Scholar] [CrossRef]
- Tomida, H.; Fujii, T.; Furutani, N.; Michihara, A.; Yasufuku, T.; Akasaki, K.; Maruyama, T.; Otagiri, M.; Gebicki, J.M.; Anraku, M. Antioxidant properties of some different molecular weight chitosans. Carbohyd. Res. 2009, 344, 1690–1696. [Google Scholar] [CrossRef] [PubMed]
- Karunakaran, G.; Suriyaprabha, R.; Manivasakan, P.; Yuvakkumar, R.; Rajendran, V.; Prabu, P.; Kannan, N. Effect of nanosilica and silicon sources on plant growth promoting rhizobacteria, soil nutrients and maize seed germination. IET Nanobiotechnol. 2013, 7, 70–77. [Google Scholar] [CrossRef] [PubMed]
- Sabry, A.H.; Ragaei, M. Nanobiotechnology applications in plant protection. In Nanotechnology in the Life Sciences; Abd-Elsalam, K.A., Prasad, R., Eds.; Springer: Cham, Switzerland, 2018; pp. 1–24. [Google Scholar]
- Siddiqui, M.H.; Al-Whaibi, M.H. Role of nano-SiO2 in germination of tomato (Lycopersicum esculentumseeds Mill.). Saudi J. Biol. Sci. 2014, 21, 13–17. [Google Scholar] [CrossRef] [PubMed]
- Fry, W. Phytophthora infestans: The plant (and Rgene) destroyer. Mol. Plant Pathol. 2008, 9, 385–402. [Google Scholar] [CrossRef] [PubMed]
- Bourke, A. Potato late blight in Europe in 1845: The scientific controversy. In Phytophthora; Lucas, J.A., Shattock, R.D., Shaw, D.S., Cooke, L.R., Eds.; Cambridge University Press: New York, NY, USA, 1991; pp. 12–24. [Google Scholar]
- Nguyen, N.T.; Hoang, D.Q.; Nguyen, N.D.; Nguyen, Q.H.; Nguyen, D.H. Preparation, characterization, and antioxidant activity of water-soluble oligochitosan. Green Process. Synth. 2017, 6, 461–468. [Google Scholar] [CrossRef]
- Nguyen, N.T.; Nguyen, D.H.; Pham, D.D.; Dang, V.P.; Nguyen, Q.H.; Hoang, D.Q. New oligochitosan-nanosilica hybrid materials: Preparation and application on chili plants for resistance to anthracnose disease and growth enhancement. Polym. J. 2017, 49, 861–869. [Google Scholar] [CrossRef]
- Dang, V.P.; Bui, D.D.; Le, N.A.T.; Hoang, V.T.; Nguyen, Q.H. Preparation and foliar application of oligochitosan—Nanosilica on the enhancement of soybean seed yield. Int. J. Environ. Agric. Biotechnol. 2017, 2, 421–428. [Google Scholar]
- Kumbar, B. Standardization of specific media for Phytophthora infestans. Glob. J. Bio-Sci. Biotechnol. 2017, 6, 374–376. [Google Scholar]
- CLSI. Methods for dilution antimicrobial susceptibility tests for bacteria that grow aerobically. In CLSI Document M07-A9, 9th ed.; CLSI: Wayne, PA, USA, 2012. [Google Scholar]
- Wang, W.; Martin, J.C.; Zhang, N.; Ma, C.; Han, A.; Sun, L. Harvesting silica nanoparticles from rice husks. J. Nanopart. Res. 2011, 13, 6981–6990. [Google Scholar] [CrossRef]
- Martinez, J.R.; Ruiz, F.; Vorobiev, Y.; Vorobiev, Y.V.; Pérez-Robles, F.; Gonzále-Hernánde, J. Infrared spectroscopy analysis of the local atomic structure in silica prepared by sol-gel. J. Chem. Phys. 1998, 109, 7511–7514. [Google Scholar] [CrossRef]
- Fernandes, I.J.; Calheiro, D.; Kieling, A.G.; Moraes, C.A.M.; Rocha, T.L.A.C.; Brehm, F.A.; Modolo, R.C.E. Characterization of rice husk ash produced using different biomass combustion techniques for energy. Fuel 2016, 165, 351–359. [Google Scholar] [CrossRef]
- Pushpamalar, V.; Langford, S.J.; Ahmad, M.; Lim, Y.Y. Optimization of reaction conditions for preparing carboxymethyl cellulose from sago waste. Carbohyd. Polym. 2006, 64, 312–318. [Google Scholar] [CrossRef]
- Zhang, L.; Jin, Y.; Liu, H.; Du, Y. Structure and control release of chitosan/carboxymethyl cellulose microcapsules. J. Appl. Polym. Sci. 2001, 82, 584–592. [Google Scholar] [CrossRef]
- Biswal, D.R.; Singh, R.P. Characterisation of carboxymethyl cellulose and polyacrylamide graft copolymer. Carbohyd. Polym. 2004, 57, 379–387. [Google Scholar] [CrossRef]
- Al-Mulla, A.; Al-Sagheer, F. Determination of kinetic parameters for the degradation of chitosan/silica hybrid nano composites. J. Polym. Environ. 2013, 21, 504–511. [Google Scholar] [CrossRef]
- Jiang, M.; Karasawa, T.; Steyger, P.S. Aminoglycoside-induced cochleotoxicity: A Review. Front. Cell. Neurosci. 2017, 11, 308. [Google Scholar] [CrossRef] [PubMed]
- Kim, S.K.; Rajapakse, N. Enzymatic production and biological activities of chitosan oligosaccharides (COS): A review. Carbohyd. Polym. 2005, 62, 357–368. [Google Scholar] [CrossRef]
- Hirano, S.; Nagao, N. Effects of chitosan, pectic acid, lysozyme, and chitinase on the growth of several Phytopathogens. Agric. Biol. Chem. 1989, 53, 3065–3066. [Google Scholar]
- Gill, S.R.; Fouts, D.E.; Archer, G.L.; Mongodin, E.F.; DeBoy, R.T.; Ravel, J.; Paulsen, I.T.; Kolonay, J.F.; Brinkac, L.; Beanan, M.; et al. Insights on evolution of virulence and resistance from the complete genome analysis of an early methicillin-resistant Staphylococcus aureus strain and a biofilm-producing methicillin-resistant Staphylococcus epidermidis strain. J. Bacteriol. 2005, 187, 2426–2438. [Google Scholar] [CrossRef] [PubMed]
- Capeletti, L.B.; de Oliveira, L.F.; de Almeida Gonçalves, K.; de Oliveira, J.F.A.; Saito, Â.; Kobarg, J.; Santos, J.H.Z.; Cardoso, M.B. Tailored silica-antibiotic nanoparticles: Overcoming bacterial resistance with low cytotoxicity. Langmuir 2014, 30, 7456–7464. [Google Scholar]
- Salem, H.F.; Eid, K.A.M.; Sharaf, M.A. Formulation and evaluation of silver nanoparticles as antibacterial and antifungal agentswitha minimal cytotoxic effect. Int. J. Drug Deliv. 2011, 3, 293–304. [Google Scholar]
- Derbalah, A.; Shenashen, M.; Hamza, A.; Mohamed, A.; Safty, S.E. Antifungal activity of fabricated mesoporous silica nanoparticles against early blight of tomato. Egypt. J. Basic Appl. Sci. 2018, 5, 145–150. [Google Scholar] [CrossRef]
- Kang, S.W.; Kim, S.W. New antifungal activity of penicillic acid against Phytophthora species. Biotechnol. Lett. 2004, 26, 695–698. [Google Scholar] [CrossRef] [PubMed]
- Frisvad, J.C. A critical review of producers of small lactone mycotoxins: Patulin, penicillic acid and moniliformin. World Mycotoxin J. 2018, 11, 73–100. [Google Scholar] [CrossRef]

| Concentration of Antifungal Agent (mg L−1) | The Average Inhibition Zone Diameter (mm) | |||
|---|---|---|---|---|
| CTS1 | nSiO2 | OCS1 | OCS2 | |
| 600 | 0.00 ± 0.00 | 0.00 ± 0.00 | 0.00 ± 0.00 | 0.00 ± 0.00 |
| 800 | 0.00 ± 0.00 | 0.00 ± 0.00 | 0.00 ± 0.00 | 0.00 ± 0.00 |
| 1000 | 0.00 ± 0.00 | 0.00 ± 0.00 | 0.00 ± 0.00 | 0.00 ± 0.00 |
| 1200 | 6.83 ± 0.17 | 7.77 ± 0.15 | 0.00 ± 0.00 | 0.00 ± 0.00 |
| 1400 | 7.17 ± 0.17 | 8.00 ± 0.00 | 8.33 ± 0.33 | 9.77 ± 0.39 |
| 1600 | 6.83 ± 0.17 | 8.83 ± 0.33 | 10.67 ± 0.93 | 10.17 ± 0.17 |
| 1800 | 6.67 ± 0.17 | 9.77 ± 0.15 | 13.83 ± 0.33 | 12.00 ± 0.29 |
| Concentration of Antifungal Agent (mg L−1) | OCS3 | OCS1/nSiO2 | OCS2/nSiO2 | OCS3/nSiO2 |
| 600 | 0.00 ± 0.00 | 0.00 ± 0.00 | 0.00 ± 0.00 | 0.00 ± 0.00 |
| 800 | 0.00 ± 0.00 | 10.17 ± 0.17 | 9.67 ± 0.17 | 8.00 ± 0.50 |
| 1000 | 0.00 ± 0.00 | 11.83 ± 0.33 | 11.50 ± 0.29 | 10.00 ± 0.76 |
| 1200 | 0.00 ± 0.00 | 12.67 ± 0.17 | 12.33 ± 0.33 | 10.50 ± 0.50 |
| 1400 | 10.17 ± 0.44 | 13.97 ± 0.30 | 13.67 ± 0.17 | 11.67 ± 0.67 |
| 1600 | 13.33 ± 0.88 | 15.17 ± 0.60 | 14.83 ± 0.17 | 13.83 ± 0.44 |
| 1800 | 14.00 ± 1.53 | 17.17 ± 0.60 | 16.17 ± 0.44 | 14.83 ± 0.44 |
© 2019 by the authors. Licensee MDPI, Basel, Switzerland. This article is an open access article distributed under the terms and conditions of the Creative Commons Attribution (CC BY) license (http://creativecommons.org/licenses/by/4.0/).
Share and Cite
Nguyen, T.N.; Huynh, T.N.; Hoang, D.; Nguyen, D.H.; Nguyen, Q.H.; Tran, T.H. Functional Nanostructured Oligochitosan–Silica/Carboxymethyl Cellulose Hybrid Materials: Synthesis and Investigation of Their Antifungal Abilities. Polymers 2019, 11, 628. https://doi.org/10.3390/polym11040628
Nguyen TN, Huynh TN, Hoang D, Nguyen DH, Nguyen QH, Tran TH. Functional Nanostructured Oligochitosan–Silica/Carboxymethyl Cellulose Hybrid Materials: Synthesis and Investigation of Their Antifungal Abilities. Polymers. 2019; 11(4):628. https://doi.org/10.3390/polym11040628
Chicago/Turabian StyleNguyen, Thuy N, Thu NM Huynh, DongQuy Hoang, Dai Hai Nguyen, Quoc Hien Nguyen, and Thai Hoa Tran. 2019. "Functional Nanostructured Oligochitosan–Silica/Carboxymethyl Cellulose Hybrid Materials: Synthesis and Investigation of Their Antifungal Abilities" Polymers 11, no. 4: 628. https://doi.org/10.3390/polym11040628
APA StyleNguyen, T. N., Huynh, T. N., Hoang, D., Nguyen, D. H., Nguyen, Q. H., & Tran, T. H. (2019). Functional Nanostructured Oligochitosan–Silica/Carboxymethyl Cellulose Hybrid Materials: Synthesis and Investigation of Their Antifungal Abilities. Polymers, 11(4), 628. https://doi.org/10.3390/polym11040628

